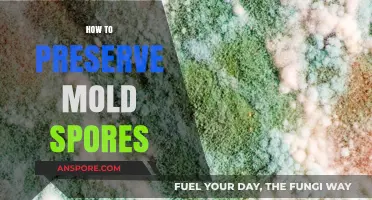
Effective Techniques for Preserving Mold Spores Safely and Efficiently

Propagating mini ferns from spores is a rewarding yet intricate process that allows gardeners to cultivate these delicate plants from their earliest stage. Unlike traditional methods of division or cuttings, spore propagation involves collecting and sowing the microscopic reproductive units found on the undersides of mature fern fronds. This method requires patience and precision, as spores are incredibly small and sensitive to environmental conditions. By creating a controlled, humid environment and using sterile techniques, enthusiasts can successfully germinate spores into tiny gametophytes, which eventually develop into new fern plants. This approach not only expands your fern collection but also deepens your understanding of their fascinating life cycle.
| Characteristics | Values |
|---|---|
| Spores Collection | Collect spores from mature fern fronds (underside) when they turn brown. Store in a paper envelope. |
| Substrate Preparation | Use a well-draining, sterile medium like peat moss, perlite, or vermiculite. |
| Container Type | Shallow trays or pots with drainage holes. |
| Sowing Depth | Lightly sprinkle spores on the surface; do not bury them. |
| Humidity Requirements | Maintain high humidity (80-90%) using a clear plastic dome or lid. |
| Temperature Range | Keep at 70-75°F (21-24°C) for optimal germination. |
| Light Conditions | Provide indirect, bright light; avoid direct sunlight. |
| Watering | Keep substrate consistently moist but not waterlogged. |
| Germination Time | Spores typically germinate in 3-6 weeks, depending on conditions. |
| Prothallus Stage | Tiny green heart-shaped prothalli develop; keep conditions stable. |
| Fern Development | Young fern fronds emerge from prothalli after 2-3 months. |
| Transplanting | Once ferns have several fronds, transplant carefully into individual pots. |
| Aftercare | Maintain humidity and avoid overwatering during early growth stages. |
| Success Rate | Varies; patience and consistent care improve success. |
| Challenges | Contamination, improper humidity, and temperature fluctuations. |
What You'll Learn
- Harvesting Mature Spores: Identify ripe sori, gently collect spores using a paper fold, store in a dry container
- Preparing the Substrate: Mix peat moss, perlite, and sand, sterilize to prevent contamination, ensure proper drainage
- Sowing Spores: Sprinkle spores evenly on damp substrate, avoid overcrowding, cover with plastic for humidity
- Germination Conditions: Maintain 70-75°F, indirect light, mist daily, monitor for prothalli growth in 2-6 weeks
- Caring for Young Ferns: Transplant when fronds appear, keep soil moist, provide shade, and gradually acclimate to light

Harvesting Mature Spores: Identify ripe sori, gently collect spores using a paper fold, store in a dry container
Mature fern spores are nature's tiny time capsules, each one a potential new plant waiting for the right conditions to awaken. To harness this potential, you must first identify the ripe sori—those clusters of spore cases often found on the undersides of fern fronds. Ripe sori typically appear as brown or golden dots, signaling that the spores within are ready for collection. This visual cue is your green light to proceed, ensuring you harvest at the optimal moment for successful propagation.
Once you’ve spotted the ripe sori, the next step is to collect the spores with precision and care. A simple yet effective method involves using a paper fold as your tool. Gently slide a small piece of paper under the sori and lightly tap or brush the frond. The mature spores will dislodge and fall onto the paper, where they can be carefully funneled into a container. This technique minimizes damage to the frond and ensures a clean collection of spores, free from debris or immature particles.
Storage is a critical but often overlooked step in the spore-harvesting process. After collecting, transfer the spores to a dry, airtight container, such as a small glass vial or envelope. Moisture is the enemy here, as it can cause the spores to clump or germinate prematurely. Label the container with the fern species and collection date for future reference. Stored properly, fern spores can remain viable for several years, giving you ample time to plan your propagation efforts.
While the process may seem straightforward, there are nuances to master. For instance, not all sori mature at the same rate, so inspect the frond closely to ensure you’re only collecting from ripe clusters. Additionally, practice makes perfect—the first few attempts may yield fewer spores than expected, but with patience and attention to detail, you’ll soon become adept at this delicate task. Harvesting mature spores is both an art and a science, blending observation, precision, and respect for the plant’s natural processes.
Mastering Spore: Copying Parts for Creative Creature Design
You may want to see also

Preparing the Substrate: Mix peat moss, perlite, and sand, sterilize to prevent contamination, ensure proper drainage
Creating the ideal substrate is a critical step in propagating mini ferns from spores, as it directly influences germination success and seedling health. The goal is to mimic the fern’s natural habitat while ensuring sterility and proper drainage. Start by mixing equal parts peat moss, perlite, and sand. Peat moss retains moisture, perlite improves aeration, and sand enhances drainage—a trio that balances hydration and oxygenation for delicate spores. This combination also prevents compaction, allowing fragile roots to develop unimpeded.
Sterilization is non-negotiable. Spores are highly susceptible to fungal and bacterial contamination, which can decimate your efforts. To sterilize, preheat your oven to 180°F (82°C) and spread the substrate mixture on a baking sheet. Bake for 30 minutes, stirring halfway through to ensure even heat distribution. Alternatively, microwave the dampened mixture in a microwave-safe container for 2–3 minutes on high, pausing to stir every minute. Allow the substrate to cool completely before use—residual heat can kill spores.
Proper drainage is equally vital. Fern spores require consistent moisture but despise waterlogging. Test your substrate by squeezing a handful; it should hold together but release water readily. If it feels too dense, increase the perlite or sand ratio. Too crumbly? Add more peat moss. Aim for a texture akin to damp sponge cake—firm yet yielding. This balance ensures spores remain hydrated without suffocating in excess water.
Practical tips can elevate your substrate preparation. Sift the mixture through a fine mesh to remove lumps and ensure uniformity. Store any unused sterilized substrate in an airtight container for future use, but note its shelf life is limited—use within 2–3 months. When sowing spores, lightly press them onto the surface without burying them; they require light to germinate. Finally, maintain humidity by covering the container with a clear lid or plastic wrap, creating a mini greenhouse effect.
In summary, preparing the substrate is a blend of science and precision. By mixing peat moss, perlite, and sand in equal parts, sterilizing thoroughly, and ensuring optimal drainage, you create a fertile foundation for spore germination. Each step, from oven sterilization to texture testing, is deliberate—designed to foster the fragile beginnings of mini ferns. Master this process, and you’ll set the stage for thriving, vibrant ferns from the very start.
Can Mold Spores Trigger Ringworm? Debunking Myths and Facts
You may want to see also

Sowing Spores: Sprinkle spores evenly on damp substrate, avoid overcrowding, cover with plastic for humidity
The delicate dance of fern propagation begins with a sprinkle—a careful, measured gesture that sows the seeds of future growth. Spores, those microscopic marvels, require a precise environment to thrive. Imagine a canvas of damp substrate, a nurturing bed awaiting its artists’ touch. Here, the spores must be distributed evenly, like stars scattered across a night sky, each with room to breathe and grow. Overcrowding is the enemy; it stifens growth and invites competition where collaboration should reign. A light hand, a steady motion, and a keen eye ensure each spore finds its place without jostling for space.
The substrate itself is a character in this story—damp but not drenched, a Goldilocks zone of moisture that cradles the spores without drowning them. Peat moss mixed with perlite or vermiculite often serves as an ideal medium, retaining moisture while allowing air to circulate. Once the spores are sown, the stage is set for their transformation. Covering the container with a clear plastic dome or wrap creates a miniature greenhouse, trapping humidity and warmth—conditions reminiscent of the fern’s native habitat. This enclosure becomes a sanctuary, shielding the spores from the whims of the outside world while fostering their development.
Yet, even with these precautions, success is not guaranteed. Spores are finicky, their germination rates influenced by factors like temperature, light, and air quality. A consistent temperature between 70–75°F (21–24°C) and indirect, filtered light mimic the understory conditions ferns adore. Patience is paramount; germination can take weeks, even months, as the spores awaken and send forth their first prothalli—tiny, heart-shaped structures that herald the next phase of growth. This waiting game tests the gardener’s resolve but rewards those who persevere with the sight of fledgling ferns unfurling their fronds.
For the meticulous gardener, record-keeping becomes an ally. Note the date of sowing, the substrate composition, and environmental conditions to refine the process over time. Labeling containers with these details ensures clarity as weeks turn into months. Mist the substrate gently to maintain moisture, but avoid overwatering, which can lead to mold or rot. This balance of care and restraint is the essence of successful spore sowing—a practice that blends science with art, precision with intuition.
In the end, sowing fern spores is an act of faith, a commitment to nurturing life from its most rudimentary form. It demands attention to detail, an understanding of nature’s rhythms, and a willingness to learn from both triumphs and setbacks. When done right, the reward is not just a new fern but a deeper connection to the intricate beauty of plant propagation. Each spore, once a speck of potential, becomes a testament to the gardener’s skill and the resilience of life itself.
Unlocking Bliss Spores in Baldur's Gate 3: A Comprehensive Guide
You may want to see also

Germination Conditions: Maintain 70-75°F, indirect light, mist daily, monitor for prothalli growth in 2-6 weeks
Creating the ideal environment for fern spore germination is a delicate balance of temperature, light, moisture, and patience. The sweet spot lies between 70-75°F (21-24°C), a range that mimics the warm, humid conditions ferns thrive in naturally. This temperature window is crucial because it accelerates enzymatic activity within the spores, kickstarting the metabolic processes necessary for growth without causing stress or desiccation. A consistent thermostat or a seedling heat mat can help maintain this range, especially in cooler climates or during fluctuating seasons.
Light plays a dual role in this process: it must be present but not overpowering. Indirect light, such as that filtered through a sheer curtain or placed a few feet away from a north-facing window, provides the energy needed for photosynthesis without scorching the delicate prothalli. Direct sunlight can be lethal, as it raises the surface temperature of the soil and dries out the spores before they can germinate. Think of it as creating a dappled forest floor effect—enough light to guide growth, but not so much that it overwhelms.
Moisture is the lifeblood of spore germination, and daily misting is non-negotiable. Use a fine-mist spray bottle to gently moisten the soil surface, ensuring it remains consistently damp but not waterlogged. Overwatering can lead to fungal growth or rot, while underwatering will halt germination entirely. The goal is to replicate the humidity of a tropical understory, where ferns naturally propagate. A humidity dome or a tray of water with pebbles can supplement misting, but the daily ritual of misting also allows you to inspect progress and maintain a hands-on connection with the process.
Monitoring for prothalli growth is both an art and a science. These heart-shaped structures, the gametophyte stage of the fern’s life cycle, typically emerge within 2-6 weeks under optimal conditions. However, this timeline is not set in stone; factors like spore viability, humidity levels, and temperature consistency can influence timing. Keep a journal to track changes, noting when the first prothalli appear and how they develop. This not only helps you refine your technique for future attempts but also deepens your understanding of the fern’s life cycle. Patience is key—rushing or over-inspecting can disrupt the delicate ecosystem you’ve created.
In practice, achieving these conditions requires attention to detail and adaptability. For instance, if you notice mold forming despite proper misting, reduce humidity slightly and ensure adequate air circulation. If prothalli fail to appear after six weeks, reassess temperature stability and light exposure. Each failure is a lesson, and each success a testament to the precision of nature’s design. By maintaining 70-75°F, providing indirect light, misting daily, and vigilantly monitoring growth, you’re not just propagating ferns—you’re participating in a millennia-old process that connects you to the natural world.
Can Ringworm Spores Contaminate Your Vacuum? Facts and Prevention Tips
You may want to see also

Caring for Young Ferns: Transplant when fronds appear, keep soil moist, provide shade, and gradually acclimate to light
Transplanting young ferns at the right moment is crucial for their survival and growth. Wait until the first fronds appear, typically 4 to 6 weeks after spore germination, before moving them to individual pots. This ensures the fern has developed a sufficient root system to support itself. Use a well-draining, peat-based soil mix and a small container with drainage holes to prevent waterlogging, which can quickly kill delicate young roots.
Maintaining consistent moisture is essential for young ferns, as they are highly sensitive to drying out. Water lightly but frequently, keeping the soil evenly moist but not soggy. A gentle misting with a spray bottle can help maintain humidity around the plant, mimicking the fern’s natural habitat. Avoid overhead watering, as this can damage the emerging fronds. For best results, use distilled or rainwater, as ferns are often sensitive to the chemicals in tap water.
Shade is a young fern’s best friend. Direct sunlight can scorch their tender fronds, so place them in a bright, indirect light or under a sheer curtain to filter the rays. If growing indoors, a north-facing window is ideal. Outdoors, position them under taller plants or use shade cloth to create a protective environment. Gradually increase light exposure over 2–3 weeks to acclimate the fern, ensuring it can photosynthesize effectively without stress.
Acclimating young ferns to brighter light is a delicate process that requires patience. Start by moving them to a slightly brighter spot for 1–2 hours daily, gradually increasing the duration by 30-minute increments each week. Monitor for signs of stress, such as yellowing or wilting fronds, and adjust accordingly. This gradual transition prepares the fern for its eventual home, whether in a sunlit garden or a well-lit room, ensuring it thrives long-term.
Install and Play Spore on Windows 10: A Step-by-Step Guide
You may want to see also
Frequently asked questions
To collect spores, wait until the fern's undersides develop small, brown or orange dots (sporangia). Place a mature frond in a paper bag or envelope, fold it closed, and leave it undisturbed for a week. The spores will drop onto the paper, which you can then use for sowing.
Use a sterile, well-draining medium like a mix of peat moss and perlite or a commercial seed-starting mix. Ensure the medium is fine-textured to allow the tiny spores to make good contact with the surface.
After sowing, lightly press the spores into the surface of the medium but do not bury them. Keep the medium consistently moist and provide high humidity by covering the container with a clear plastic dome or placing it in a terrarium. Maintain a warm temperature (around 70-75°F or 21-24°C).
Germination can take several weeks to a few months, depending on the species and conditions. Prothalli (the first stage of fern growth) will appear first, followed by tiny fern seedlings. Be patient and maintain consistent care during this period.
Yes, mini ferns can be propagated from spores indoors. Ensure you provide adequate humidity, warmth, and indirect light. Using a grow light or placing the container near a bright, indirect light source can help support healthy growth.